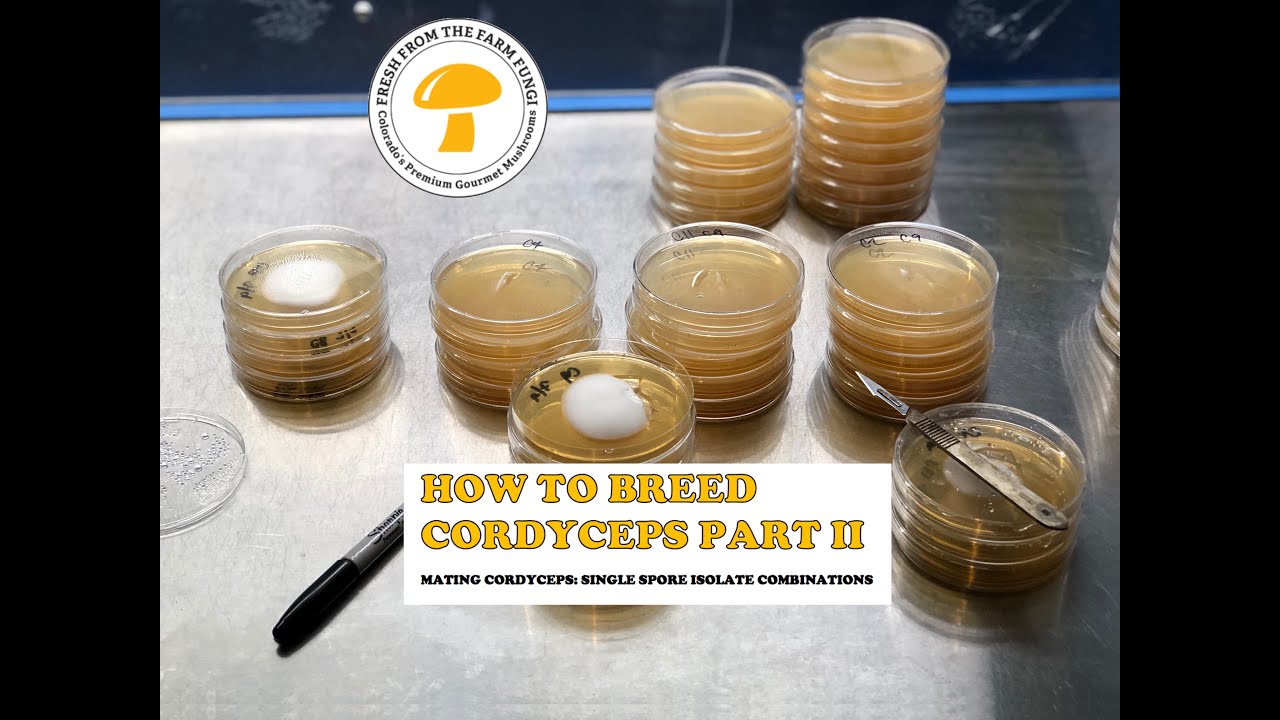
How to Breed Cordyceps Part 2: Combining single ascospore isolates

Cordyceps project week 4 update: Transfering mated pairings to slants for long term storage
Автор: Fresh from the Farm Fungi
Загружено: 2020-08-05
Просмотров: 3569
Описание: In this video we show our procedure for keeping our cordyceps cultures viable long term by storing them on MEA agar slants! For more information visit our website http://freshfromthefarmfungi.com to purchase our living mycelium cultures visit our ETSY shop FRESH FUNGI https://www.etsy.com/shop/freshfungi MUSHLOVE
Повторяем попытку...

Доступные форматы для скачивания:
Скачать видео
-
Информация по загрузке: